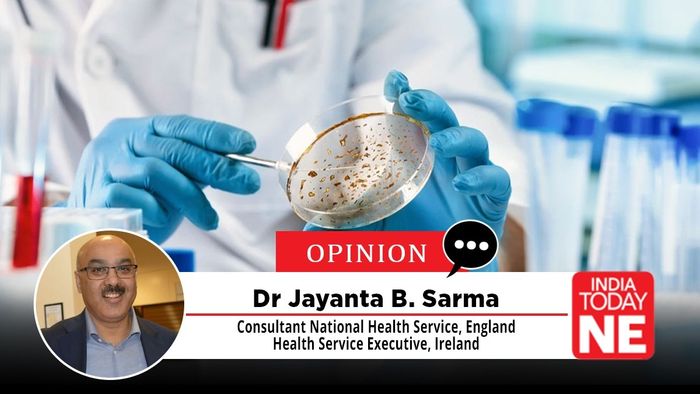

Living with Superbugs: Notes of a Participant-Observer across Two Worlds
Antimicrobial resistance is often described as a microbial arms race. In reality, it behaves more like an audit of our institutions.
- Feb 12, 2026,
- Updated Feb 12, 2026, 4:45 PM IST
Antimicrobial resistance is often described as a microbial arms race. In reality, it behaves more like an audit of our institutions.
I first came to microbiology in the mid-1990s, not through crisis but curiosity. In Manchester, as a young doctor from Guwahati, I was drawn to the invisible world revealed by PCR machines and molecular signatures — the idea that a few strands of DNA could explain disease, survival, and failure. It felt clean, precise, and intellectually intoxicating.
My MSc research compared two PCR approaches to detect human papillomavirus DNA in cervical samples taken from sex workers in Kolkata. Even then, a contradiction was impossible to ignore. The molecular tools were sophisticated; the social reality was not. The science was cutting-edge; the lives it touched were shaped by poverty, stigma, and limited access to care. I did not yet have the language for it, but the seed was planted: microbiology never exists in isolation from systems.
Coming home to reality
In 1996, I returned to Guwahati Medical College and Hospital as a junior teaching faculty member. The contrast with Manchester was immediate and sobering. The molecular world I had inhabited abroad existed here only in fragments. What dominated daily clinical life were overcrowded wards, empiric antibiotic use, limited diagnostics, and infections that patients acquired because they were hospitalised.
Infection control was aspirational. Formalised policies were limited, structured surveillance was weak, and there was no fully developed framework with clear authority or accountability. A small group of committed clinicians tried to navigate complex realities without a clear roadmap or sustained institutional backing.Antibiotics became the immediate response to uncertainty. Over time, infection rates that should have alarmed began to feel routine. That was when I realised microbiology is not only about identifying organisms; it is about building systems capable of responding to them consistently.
This was my first real lesson in how systems fail. When institutions cannot change behaviour, they quietly redefine failure as baseline reality.
Learning how systems behave when they work
In 1997, I returned to the UK to train formally in Medical Microbiology, beginning in Edinburgh and later continuing in Newcastle. I completed specialist training and became a Member of the Royal College of Pathologists in 2003, the same year I was appointed Consultant Microbiologist at Northumbria Healthcare NHS Foundation Trust.
Here, I encountered a different ecosystem. Laboratories were integrated with clinical teams. Surveillance was routine. Data were discussed openly. Infection-control teams had authority — not just responsibility. Decisions were sometimes unpopular, but they were enforceable.
The difference was not intelligence, dedication, or compassion. It was institutional design.
Living between two worlds
Despite a growing consultant career in the NHS, my intellectual and emotional engagement with Guwahati never ceased. The questions that unsettled me there — why hospital infections persisted, why antibiotics substituted for systems, why “endemicity” became an excuse — continued to shape my thinking.
This led to my doctoral work, completed in 2010, focused on the realities of infection control in a teaching hospital in Northeast India. One outcome was a detailed assessment of infection-control constraints at Guwahati Medical College: overcrowding, limited isolation capacity, fragile surveillance, and heavy empiric antibiotic use. It was not written as an indictment, but as an attempt to describe reality honestly.
Then came a moment that transformed unease into anxiety.
When NDM-1 reached Guwahati
Around the same time, Carbapenem-resistant organisms — including what would soon be known as NDM-1 producers — began to appear in isolates linked to Guwahati. This was not an abstract threat. Carbapenems were supposed to be the antibiotics of last resort. Here was a resistance mechanism that rendered them largely ineffective.
The anxiety was not academic. It was operational and ethical.
How do you treat infections resistant to nearly everything when isolation capacity is limited, stewardship is fragile, and surveillance is delayed? How do you reassure clinicians — or patients — when the therapeutic cupboard is visibly thinning?
Shortly afterwards, the world woke up to NDM-1 through a multinational paper in The Lancet Infectious Diseases, on which I was a co-author. International headlines followed. For many clinicians in India, the surprise had already passed.
The lesson was stark: antimicrobial resistance is not exported by malice or incompetence, but by weak systems multiplied by movement.
Stewardship works — but not the way we like to tell the story
In the UK, my work on antibiotic stewardship and infection control showed that disciplined systems save lives. Restricting fluoroquinolones led to dramatic reductions in Clostridioides difficile infection. Universal MRSA screening coincided with falling bloodstream infection rates. Surveillance, audit, and governance worked.
It was tempting to tell a comforting story: policy defeated pathogen.
However, comfort is rarely the same as truth.
EMRSA-15 and the danger of tidy victories
By the mid-2010s, MRSA rates in the UK were declining. The dominant narrative credited infection-prevention bundles and screening programmes. It was precisely then that I undertook a genomic review of EMRSA-15, the epidemic MRSA clone that had dominated UK hospitals for years.
What the data suggested was humbling. EMRSA-15 did not simply vanish because policy succeeded. It behaved like an epidemic organism moving through a biological life cycle: emergence, dominance, stabilisation, and waning. Infection-control measures shaped that trajectory, but they did not fully explain it.
Clonal competition, fitness trade-offs, and changing antibiotic selection pressures mattered. Even in earlier evaluations of MRSA screening, declining background trends complicated causal claims.
The danger was not infection control. The danger was myth-making.
When we attribute microbial decline entirely to our interventions, we risk complacency — and surprise when the next organism behaves differently.
Drugs buy time; systems decide what happens next
Parallel work on real-world antibiotics and biomarkers reinforced the same message. Resistance can emerge without obvious misuse. Even the best drugs operate within ecological constraints. Biomarkers support judgement, but they do not replace it.
Pharmacology buys time. Governance decides whether that time is squandered.
What this means for India — now
Across decades and settings, the pattern is consistent. In resource-constrained hospitals, endemic resistance breeds fatalism. In better-resourced systems, success breeds triumphalism. Both are mistakes.
Infection control and antibiotic stewardship do not end the story. They pause it, reshape it, and buy time — if systems hold.
The most dangerous moment in antimicrobial resistance is not failure. It is premature celebration.
The quiet conclusion
From early curiosity in Manchester, through the wards of Guwahati, the laboratories of Edinburgh and Newcastle, and the governance structures of the NHS, one truth has emerged slowly:
Microbes do not outthink us — they outlast our attention spans.
Hospitals do not defeat pathogens once and for all. They apply pressure, and biology responds. Sometimes by retreating. Sometimes by reorganising. Sometimes by waiting.
The task of public health is not to declare victory, but to stay awake when the curve bends downwards — and to remember that systems, not microbes, usually decide how the story ends.